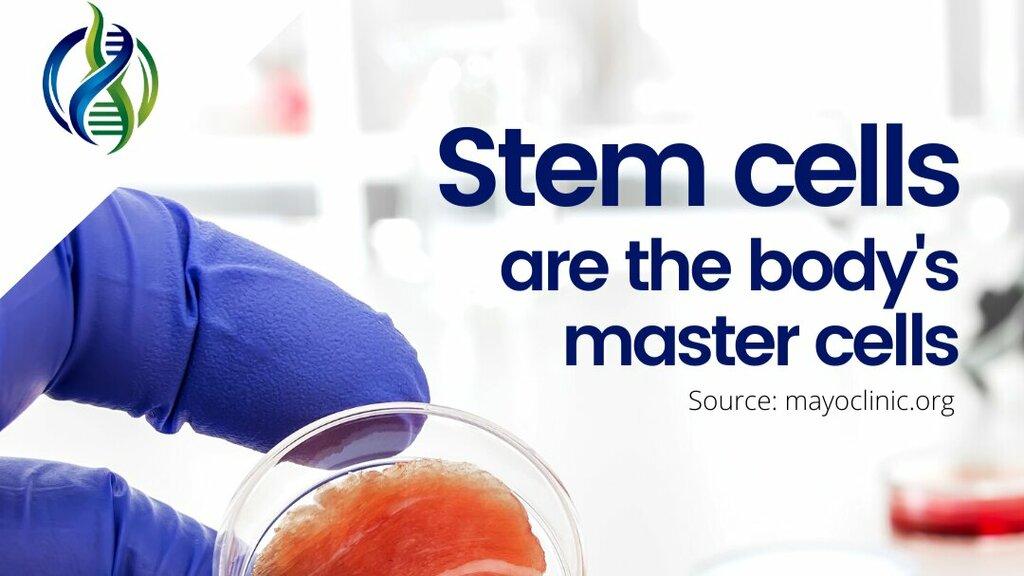

Healing Touch Oriental Medicine
Healing Touch Oriental Medicine, founded by Dr. Mary Riggin, specializes in longevity, optimal health, and a variety of holistic treatments including acupuncture, herbal formulas, and bodywork. With a focus on ancient methods and a unique approach to diagnosing health problems, the clinic aims to enhance overall wellness without the use of drugs or surgical procedures.
Offering services such as facial rejuvenation, hormone balancing, and food coaching, Healing Touch Oriental Medicine integrates traditional Chinese medicine principles to address modern health issues. The clinic seeks to uncover the underlying causes of health concerns, promoting a deeper understanding of the body's functionality and empowerment in achieving better health.
Generated from the website
Also at this address
You might also like
Partial Data by Foursquare.